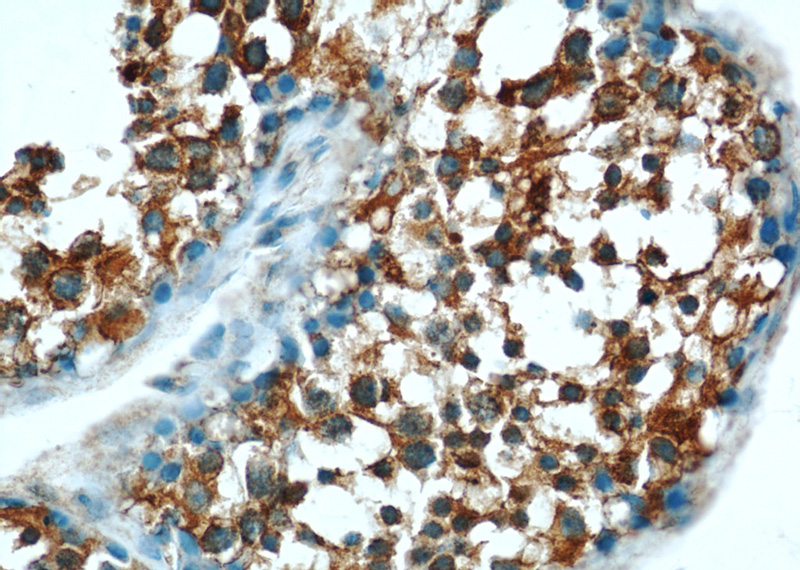
Immunohistochemical of paraffin-embedded human testis using Catalog No:110188(EIF2S2 antibody) at dilution of 1:50 (under 40x lens)

-
Product Name
EIF2S2 antibody
- Documents
-
Description
EIF2S2 Rabbit Polyclonal antibody. Positive IF detected in HepG2 cells, L02 cells. Positive IHC detected in human testis tissue, human liver tissue. Positive IP detected in mouse liver tissue. Positive WB detected in mouse liver tissue, HeLa cells, L02 cells, mouse testis tissue, PC-3 cells. Observed molecular weight by Western-blot: 50 kDa
-
Tested applications
ELISA, WB, IHC, IF, IP
-
Species reactivity
Human, Mouse; other species not tested.
-
Alternative names
DKFZp686L18198 antibody; eIF 2 beta antibody; EIF2 antibody; EIF2B antibody; EIF2beta antibody; EIF2S2 antibody
-
Isotype
Rabbit IgG
-
Preparation
This antibody was obtained by immunization of EIF2S2 recombinant protein (Accession Number: NM_003908). Purification method: Antigen affinity purified.
-
Clonality
Polyclonal
-
Formulation
PBS with 0.1% sodium azide and 50% glycerol pH 7.3.
-
Storage instructions
Store at -20℃. DO NOT ALIQUOT
-
Applications
Recommended Dilution:
WB: 1:500-1:5000
IP: 1:500-1:5000
IHC: 1:20-1:200
IF: 1:10-1:100
-
Validations

mouse liver tissue were subjected to SDS PAGE followed by western blot with Catalog No:110188(EIF2S2 antibody) at dilution of 1:1000
Immunohistochemical of paraffin-embedded human testis using Catalog No:110188(EIF2S2 antibody) at dilution of 1:50 (under 40x lens)

Immunofluorescent analysis of HepG2 cells, using EIF2S2 antibody Catalog No:110188 at 1:25 dilution and Rhodamine-labeled goat anti-rabbit IgG (red).

IP Result of anti-EIF2S2 (IP:Catalog No:110188, 4ug; Detection:Catalog No:110188 1:1000) with mouse liver tissue lysate 4000ug.
-
Background
Eukaryotic translation initiation factor 2 (eIF2) is composed of three subunits, eIF2 alpha, eIF2 beta (EIF2S2), and eIF2 gamma, which are present in equal molar amounts. eIF2 beta plays a central role in the maintenance of what is generally considered a rate-limiting step in mRNA translation. In the early steps of protein synthesis, eIF2 beta binds GTP and Met-tRNA and transfers Met-tRNA to the 40S ribosomal subunit. At the end of the initiation process, GTP bound to eIF2 beta is hydrolyzed to GDP and the eIF2/GDP complex is released from the ribosome. The exchange of GDP bound to eIF2 beta for GTP is a prerequisite to binding Met-tRNA and is mediated by eIF2 beta, which recycles the eIF2 complex for another round of initiation.
-
References
- Fittschen M, Lastres-Becker I, Halbach MV. Genetic ablation of ataxin-2 increases several global translation factors in their transcript abundance but decreases translation rate. Neurogenetics. 16(3):181-92. 2015.
- Lee GY, Haverty PM, Li L. Comparative oncogenomics identifies PSMB4 and SHMT2 as potential cancer driver genes. Cancer research. 74(11):3114-26. 2014.
Related Products / Services
Please note: All products are "FOR RESEARCH USE ONLY AND ARE NOT INTENDED FOR DIAGNOSTIC OR THERAPEUTIC USE"
